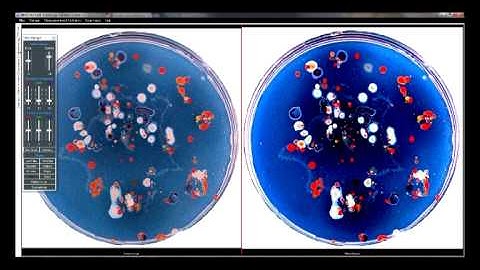
Microptik MIMIS 2014 multipurpose Image analysis software

⬇ DOWNLOAD NOW
Jika muncul iklan pop-up, tutup lalu klik tombol kembali
Download lagu MiShell, Microptik state of the art Image analysis software secara gratis hanya untuk keperluan promosi. Dukung artis favorit kamu dengan membeli musik original di iTunes atau platform resmi lainnya.
 Microptik Smart-Eye Image analysis Software
Microptik Smart-Eye Image analysis Software Microptik MIMIS 2014 multipurpose Image analysis software
Microptik MIMIS 2014 multipurpose Image analysis software Microptik Object recorded with Mesoscopy technology
Microptik Object recorded with Mesoscopy technology Microptik Object recorded with Mesoscopy technology
Microptik Object recorded with Mesoscopy technology Microptik Smart Eye LT II promotion video
Microptik Smart Eye LT II promotion video MicrOptik All purpose 3D Digital video MIcroscope (Top-Eye P1)
MicrOptik All purpose 3D Digital video MIcroscope (Top-Eye P1) Microptik MIFIS4 fiber analysis software
Microptik MIFIS4 fiber analysis software MicrOptik All purpose 3D Digital video MIcroscope (Top-Eye P3)
MicrOptik All purpose 3D Digital video MIcroscope (Top-Eye P3)